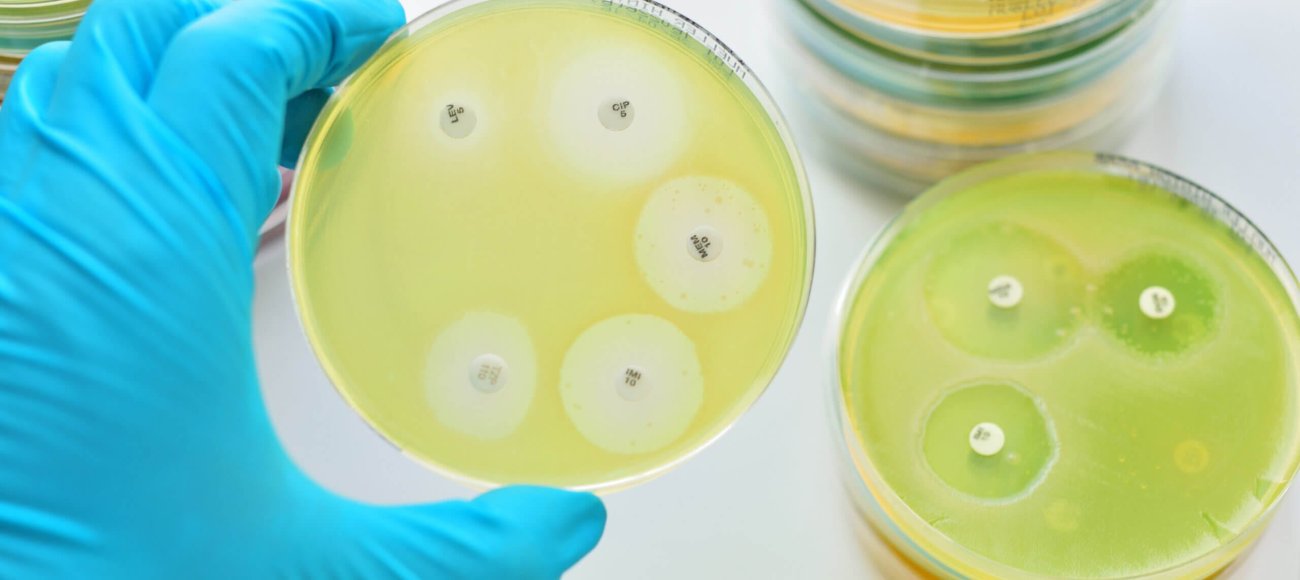
Bacterial resistance testing - MIC,ZOI and MBC

The fight against bacterial infection has been a long and challenging fight for humans and the innovations in testing bacterial resistance to available drugs have been very critical in setting treatment strategies. Traditional methods, such as the Zone of Inhibition (ZOI) and Minimum Inhibitory Concentration (MIC), have provided fundamental insights into the susceptibility of bacterial strains to antimicrobial agents. However with the increasing threat of antibiotic resistance, there has been an increase in the development of novel and refined methods that help analyze and counteract this growing threat.
This article discusses the advances in the testing of bacterial resistance focusing highly on ZOI, MIC and other relevant techniques including Minimum Bactericidal Concentration.
The Zone of Inhibition (ZOI): A Time-Tested Approach
One of the more recognizable methods for the evaluation of bacterial susceptibility towards antibiotics is the ZOI test, also known as the Kirby-Bauer method or the disc diffusion test method. Antibiotic-impregnated disks are placed over an agar plate already inoculated with the culture of bacteria targeted by the test. Bacteria will grow for a period of time, except in areas around the antibiotic disks that have suppressed their growth. This causes a clear area or the Zone of inhibition.
The diameter of the ZOI is measured and the bacterial strain is classified as susceptible, intermediately susceptible or resistant to the tested antibiotic by comparing it to available standards. This simple, convenient and cheap method offers clear visualization and recent achievements range from the development of automatic image analysis software for accurate measurement and recording of data to enhance reproducibility and minimize human error.
Importance of ZOI in Bacterial Resistance Testing
The ZOI test measures the antimicrobial efficacy of the antimicrobial agent and gives insight into the susceptibility patterns of the bacterial strain. Different sizes of the ZOI formed due to various antimicrobial agents can be compared by microbiologists, which can help in the determination of the most effective antibiotics against a particular bacterial strain and can be greatly useful for the selection of antibiotics for treatments.
Minimum Inhibitory Concentration (MIC)
Unlike ZOI that gives results qualitatively, MIC gives a much more accurate quantitative analysis of the susceptibility of bacteria to the agent. It is the minimum concentration of the antimicrobial agent at which no visible growth of the bacteria is observed.
The MIC test is done by the serial dilution method either in broth or agar plates. In this, increasing concentrations of the antimicrobial agent are added to tubes or wells inoculated with a standard quantity of bacterial inoculum. After incubation, the lowest concentration showing no visible bacterial growth is noted as the MIC. A more standardized version for this test, involving 96-well plates is known as broth microdilution and is used very commonly as it permits testing several agents on the same plate, which is very efficient.
Role of MIC in Bacterial resistance testing
MIC testing has a very vital role in the development of antibiotic stewardship programs. It helps to know the exact drug concentrations needed to combat bacterial infections and, thus avoiding drug abuse as well as the development of resistance. This very precise approach ensures that the patient will receive the most effective therapy and, at the same time, the exposure will be minimized to prevent the risk of further resistance.
The latest development in this test is the development of microfluidic chips, which reduce the use of reagents significantly and, at the same time, reduces the incubation period. Its results are obtained in hours rather than days. Automated systems, like VITEK and Phoenix, are also capable of quickly determining MICs by using advanced optical sensors and algorithms to interpret bacterial growth.
Minimum Bactericidal Concentration (MBC)
While MIC defines the concentration necessary to prevent bacterial growth, it may not necessarily infer the killing of the bacteria. MBC goes one step ahead to determine the concentration at which a particular bacterial population gets killed.
Aliquots from wells in which no visible growth is observed after MIC testing are plated on agar plates and incubated. MBC is the lowest concentration of antibiotic that kills 99.9% of the original inoculated bacteria. MBC tests are very useful for clinicians to guide their choice of treatment mainly for those infections where it is most important to eradicate the bacteria for effective cure such as in endocarditis. Efforts to automate colony counting and data analysis to limit labor and provide accuracy have continued to improve MBC testing.
Beyond ZOI and MIC: Innovations in Bacterial resistance testing
Advanced Molecular techniques
Recent development in bacterial resistance testing has gone beyond the conventional methods like ZOI and MIC. Molecular techniques like PCR (Polymerase Chain Reaction) and whole-genome sequencing are now being utilized to detect specific resistance genes from clinical samples. These provide more rapid and accurate assessment of resistance mechanisms and, therefore, a more targeted treatment.
The role of Bioinformatics
Bioinformatics has brought a revolution in the way microbial data is analyzed. It is a technology that uses high-level algorithms and software to predict resistance patterns using genetic information. Nowadays, this integration of bioinformatics and traditional testing methods allows researchers to predict how bacteria will evolve resistance. This will enable them to be proactive in the development of new antimicrobial agents.
Automation in Bacterial Resistance Testing
Automation is hugely picking up in the microbial resistance testing field. Automated systems can perform sample preparation, plating, reading results, and repetitive tasks with great precision and speed. Not only do these increase the throughput of the tests, but they minimize human error with more reliable and consistent data.
Innovations in bacterial resistance testing are imperative to our work in continuing to fight infectious diseases. Techniques like ZOI, MIC, and the emerging ones are very helpful in developing effective antimicrobials and preventing the spread of resistance. With time, these methods will become an integral part of public health strategies around the world.
At Microbial Investigations Switzerland (MIS), we provide comprehensive antimicrobial testing services designed to evaluate the efficacy of compounds and everyday products formulated to have antimicrobial effects. Our team of experienced researchers and microbiologists excels in developing and conducting tailored test procedures while delivering insightful interpretations of microbiological data and reports.
We’re committed to helping our clients achieve continuous improvement and innovation in crafting solutions that enhance well-being through our advanced microbiology testing services.
If you have any questions regarding MIC tests or other antimicrobial testing services, our experts are here to assist.